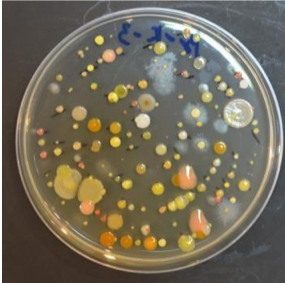
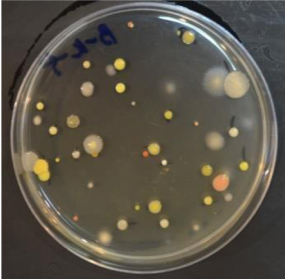
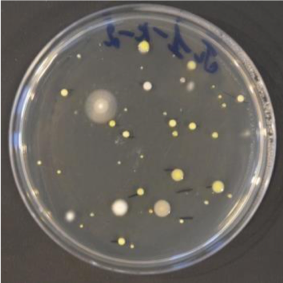

Звоните —
Ваш город
Главная — Антисептическая и антибактериальная обработка воздуха
ИЗБАВЬТЕСЬ БЫСТРО И БЕЗОПАСНО
ОТ ОПАСНЫХ БАКТЕРИЙ И ВИРУСОВ
В ПОМЕЩЕНИИ
с помощью сертифицированного оборудования прошедшего испытания в НИИ
ОТ 11 900 РУБ ПОД КЛЮЧ
Можно использовать в момент нахожденичя людей в помещении
Подходит к требованиям Роспотребнадзора по профилактике короновирусной инфекции

Проверено НИИ
при Роспотребнадзоре
при Роспотребнадзоре





ИЗБАВЬТЕСЬ БЫСТРО И БЕЗОПАСНО ОТ ОПАСНЫХ БАКТЕРИЙ, ВИРУСОВ И НЕПРИЯТНЫХ ЗАПАХОВ В ПОМЕЩЕНИИ

АБСОЛЮТНО БЕЗОПАСНО
Мы разработали и применяем эффективный и безопасный способ очистки воздуха и снижения риска заражения персонала инфекциями, передающимися воздушно-капельным и воздушно-пылевым путем
Антисептик с ароматизатором соответствуют требованиям безопасности

Основным источником микробиологического загрязнения является человек;
Системы первичной и вторичной фильтрации забора воздуха в данной ситуации не эффективны;
Большинство методов дезинфекции воздуха либо имеют ограничения по времени, либо требуют отсутствия человека на момент самой дезинфекции;
КОМПАНИЯ "ТРЕТЬЕ ЧУВСТВО" ВОШЛА В МОСКОВСКИЙ ИННОВАЦИОННЫЙ КЛАСТЕР

В данном кластере "Третье Чувство" указано в списке компаний с технологией холодная диффузия по борьбе с короновирусом в разделе по контролю санитарно–эпидемиологической ситуации


НАШЕЙ ТЕХНОЛОГИЕЙ ПОЛЬЗУЮТСЯ
ИННОВАЦИОННАЯ ТЕХНОЛОГИЯ

Аромат распыляется по принципу холодной диффузии. Самая инновационная и передовая технология в области ароматизации помещений:
Частицы аромата не оседают на поверхности, одежде и мебели, а растворяются в воздухе
В 50 раз меньше капли аэрозоля
Аромат равномерно расходится в воздушном пространстве помещения
Каждое устройство программируется под нужную концентрацию аромата в помещении
Посмотреть оборудование
93%
Эффективность снижения бактерий ОМЧ
держится на уровне 93%
держится на уровне 93%
01
ОБЩЕЕ МИКРОБНОЕ ЧИСЛО
91%
Снижение уровня частиц стафилококк эффективно на 91%
02
СТАФИЛАКОКИ
91%
Частицы плесени удаляются с эффективностью в 91%
03
ПЛЕСЕНЬ
ЭФФЕКТИВНОСТЬ СНИЖЕНИЯ БАКТЕРИЙ В ВОЗДУХЕ
АНТИСЕПТИЧЕСКАЯ ОБРАБОТКА БИЗНЕСА
с помощью распыления сертифитированного антисептического препарата нашего производства
Идеально подходит под требование Роспотребнадзора и других контролирующих органов

ИССЛЕДОВАНИЕ
Оценка эффективности технологии по снижению общего микробного числа (ОМЧ)
ОМЧ составляет
1900 КОЕ/м3
1900 КОЕ/м3
Исходные показания
Снижение ОМЧ до 93% сравнительно с исходным уровнем
Через 1 час
Снижение ОМЧ до 78% сравнительно с исходным уровнем
Через 3 часа

Снижение ОМЧ до 52% сравнительно с исходным уровнем
Через 6 часов



МЕСТА ПРИМЕНЕНИЯ
РАССЧИТАЕМ СТОИМОСТЬ АНТИСЕПТИЧЕСКОЙ ОБРАБОТКИ ВАШЕГО ПОМЕЩЕНИЯ
Заполните простую форму, наш менеджер свяжется с Вами и рассчитает стоимость обеззараживания для вашего помещения
Автосалоны
Торговые центры
Рестораны
Салоны красоты
Гостиницы
Бизнес-центры
Медицинские центры
Фитнес-центры
— бизнес становится приятнее, если у него есть свой аромат
Первый, кто применит аромат для бизнеса, тот оторвется от всех конкурентов
Джек Кенфилд
Предприниматель, автор книг, выпущенные тиражом более 500 млн штук

100% СЕРТИФИКАЦИЯ ПРОДУКЦИИ





Международный сертификат стандартов качества ISO 9001


Оборудования прошли все нормы технического регламента Таможенного союза
Сертификат соответствия
ФАТРМ
ФАТРМ


Используем профессиональное оборудование
ВАРИАНТЫ ПРИОБРЕТЕНИЯ ОБОРУДОВАНИЯ
ПОКУПКА
Вы можете приобрести оборудование и забыть о ежемесячной плате за обородование
АРЕНДА
В случае если вы хотите попробовать, или не хотите единоразово тратить большую сумму на оборудование, вы можете взять его в аренду
ОСТАЛИСЬ ВОПРОСЫ? МЫ БУДЕМ РАДЫ ОТВЕТИТЬ ВАМ!
Заполните форму , ответ придет по почте или телефону указанным в форме, в течении двух рабочих дней после обращения



